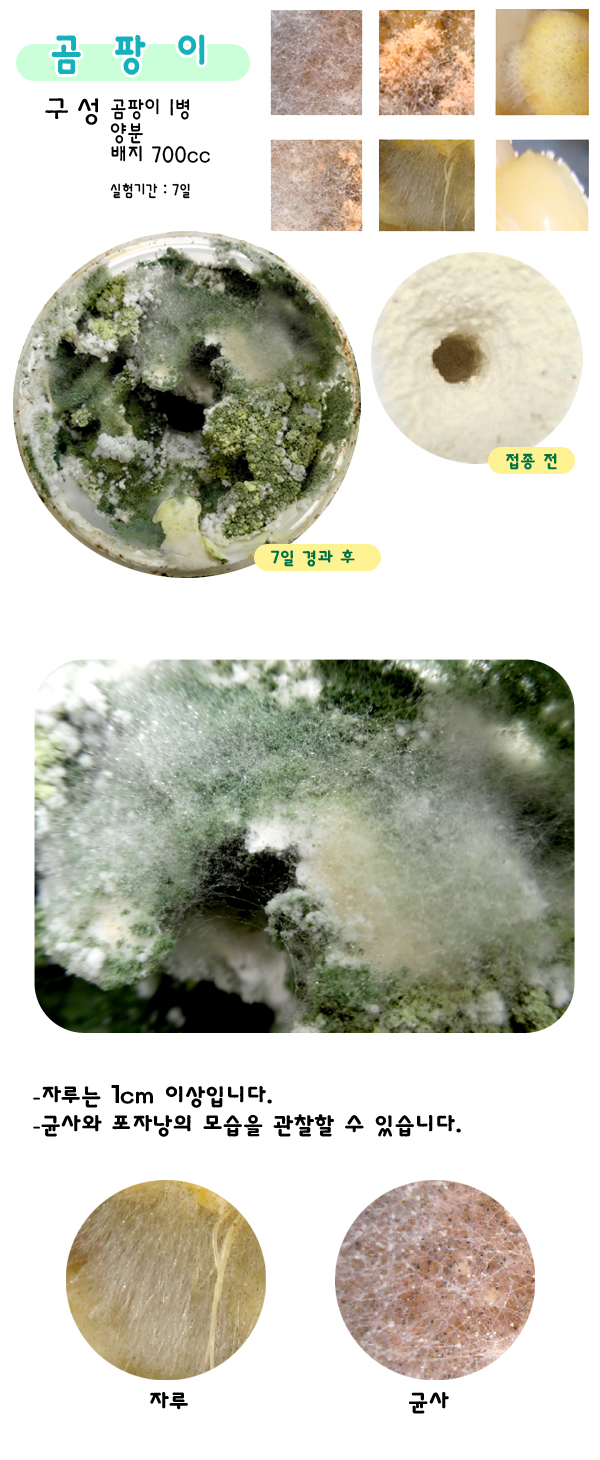

|
|
|
|
|
|
 |
홈 > 쇼핑몰 > 생물 |
|
| |
 |
내용물
자루가 발생한 곰팡이 1 병, 접종된 곰팡이 배지 1 병,누룩균 10그람,
즉석활성건조효모균 10그람,느타리버섯700 씨씨 1 병
(누룩균, 효모균은 약간의 추가 수량 가능합니다. 주문시 적어주세요)
2 병의 곰팡이가 포장됩니다.
다 자란 곰팡이 1 병, 관찰기록을 할 수 있도록 포장된 배지 1 병이 들어 있습니다.
7 일 ~15 일
우리 생활에 가장 밀접한 관계를 유지하는 균류 중 진균, 조균류,
자낭균류, 담자균류를 분류할 수 있도록 하였습니다.
곰팡이가 점령하는 과정을 짧은 시간에 기록할 수 있습니다.(사진)
간혹 여러가지의 균사가 자랄 수 있으나 환경에 가장 강한 균사가 점령합니다.
뚜껑이 있어 곰팡이가 밖으로 빠져 나가지는 못합니다.
주의사항
햇빛을 받지 않도록하고 균사를 해체하지마세요.
뚜껑을 열어 관찰하고 사진을 찍는 것은 관계없으며
습도가 유지되어 있으니 뚜껑을 닫아두세요.
병안에 곰팡이가 점령하는 속도는 약 7 일 정도의 시간이 걸리고
처음에는 환경에 적응하는 푸른색이 우점합니다.
두번째는 양분에 적합한 노란곰팡이 세번째는 ...
뚜껑을 열때 공기중에 먼지를 타고 곰팡이가 이동하니 다양하게 변화할 수도 있습니다.
아이들에게는 지금 필요한 것을 가르치는 것도 좋지만
성인이 됐을 때 사용할 수 있는 기초를 지금 가르치는 것은 어떨까요?
포자발생생물- 곰팡이,우산이끼,솔이끼,고사리 |
|

-우편번호 오류시 수기로 111-111을 입력해주세요
-오후 4시이후의 주문은 익일 발송됩니다.
-50,000원 이상 주문시 무료배송됩니다. 교내 직접 배송시는 배송비 별도 청
구하지 않습니다.
-택배는 로젠택배로 발송됩니다.
-화물택배 이용시 대신화물을 이용하며, 고속버스 택배 또한 이용가능합니
다.
-고속버스, 대신화물 이용시 당일 발송 후 예상도착시간, 차번호등을 문자로
받아보실 수 있습니다.

-생물특성상 반품/교환은 어려우며 문제가 있을 시 전화통화 후 재배송만 가
능 합니다.
-일반 택배와 달리 박스를 두 배로 강화하고 있으며 각 제품별로 특화된 포장
재를 사용합니다.
-파손제품은 확인 후 즉시 재발송합니다.

-날씨에 따라 발송날짜에 변화가 있을 수 있습니다.
-생물이므로 수시 가격 변동이 있습니다. 인터넷의 가격은 예산책정시 예시
가격입니다.
-주문시 팩스 031-965-5570 , 팩스031-963-5591로 사업자등록증과 주문
내용, 이메일 주소를 적어 보내주십시오.
-공공기관 후불주문시 주문 메모란에 후불이라고 적어주십시오.행정서류와
같이 배송됩니다.
-방문을 원하시는 경우 전화문의 후 방문해 주시기 바랍니다.
-개인 고객의 방문은 아직 허락치 않고 있으며 업무상 방문만 가능합니다.
행정주소는 공개,관리실, 사무실 주소는 비공개하니 방문시는 필히 전화 후 방문, 개인 방문 절대 안됩니다. |
 |
| 상품평 : 총 0 개 |
"균류세트-곰팡이,누룩,효모Yeast,느타리버섯" 상품의

 |
|
|
|
|
|
|
